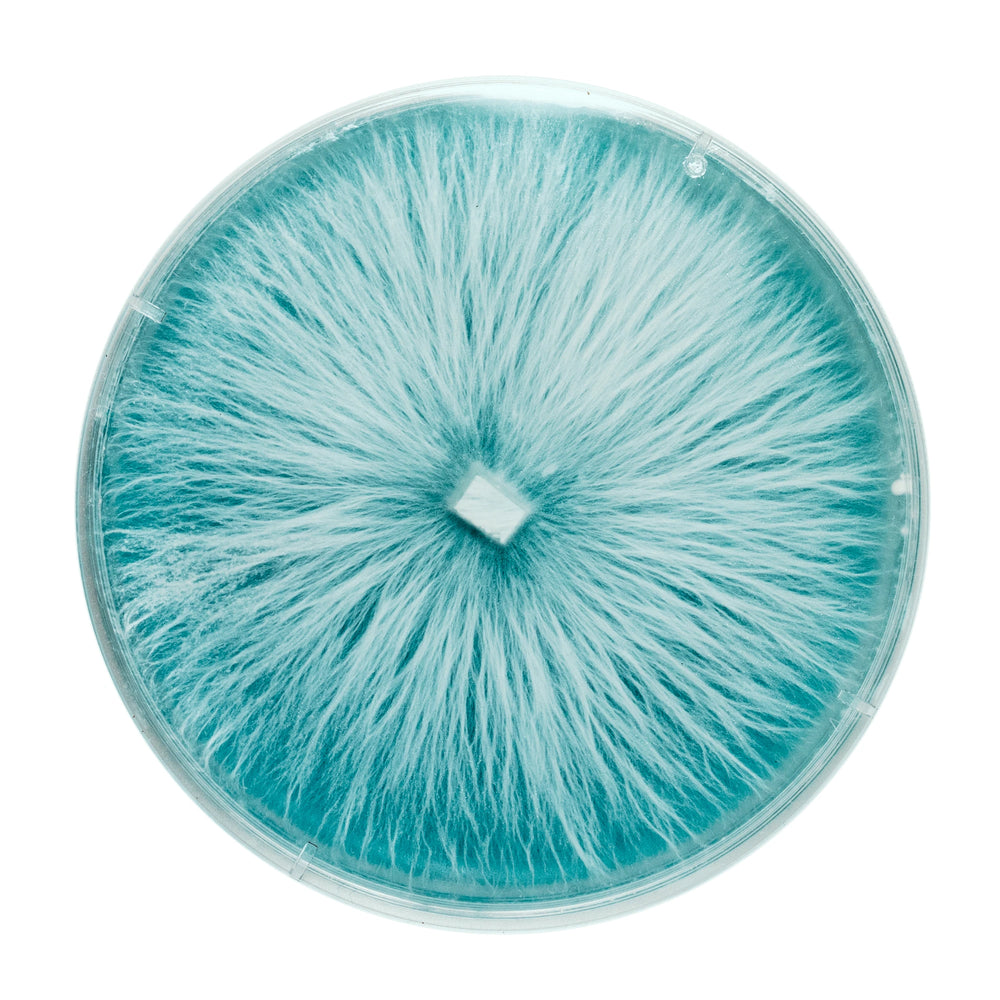
Organic Pink Oyster 90mm Culture Plate

MY Liquid Culture
Add bold color and fast growth to your setup with our Pink Oyster Mushroom Agar Plate. This vibrant strain (Pleurotus djamor) is known for its striking rose-pink clusters, warm-temperature tolerance, and incredibly quick colonization. Pink Oysters offer a rich, meaty aroma and produce beautiful, coral-like formations that stand out in any grow room. Perfect for beginners and seasoned growers looking for a reliable, visually stunning variety.
Why you'll love it
High Quality Formulation
Our cultures are made-to-order in our in-house lab using premium genetics and medical-grade petri dishes. Each culture is suspended in nutrient-rich malt extract agar, ideal for vigorous mycelial growth.
Lab-Tested Purity
Cultured under rigorous lab conditions to ensure a 100% contaminant-free experience, backed by our award-winning genetics.
Expert Quality Control
QC'd by our team of expert mycologists, each culture is individually wrapped to ensure freshness and sterility upon arrival.
Ideal for Hardwood Substrates
Pink Oyster grows optimally on hardwood-based substrates, supporting strong and healthy mycelium development.
Easy to Use
Plate cultures are accessible for all experience levels, from beginners to advanced growers.
Usage & application
Agar plates are versatile and can be used to create master bags, inoculate grain or bulk substrates, make liquid cultures, or produce additional plates. For best results, use a still-air box or laminar flow hood to keep sterility while transferring to substrates or creating additional cultures. Agar plates are an invaluable tool in mushroom cultivation, providing a stable and adaptable foundation for mycelium propagation, strain preservation, and research, essential for both hobbyists and professional cultivators.
Add bold color and fast growth to your setup with our Pink Oyster Mushroom Agar Plate. This vibrant strain (Pleurotus djamor) is known for its striking rose-pink clusters, warm-temperature tolerance, and incredibly quick colonization. Pink Oysters offer a rich, meaty aroma and produce beautiful, coral-like formations that stand out in any grow room. Perfect for beginners and seasoned growers looking for a reliable, visually stunning variety.
Why you'll love it
High Quality Formulation
Our cultures are made-to-order in our in-house lab using premium genetics and medical-grade petri dishes. Each culture is suspended in nutrient-rich malt extract agar, ideal for vigorous mycelial growth.
Lab-Tested Purity
Cultured under rigorous lab conditions to ensure a 100% contaminant-free experience, backed by our award-winning genetics.
Expert Quality Control
QC'd by our team of expert mycologists, each culture is individually wrapped to ensure freshness and sterility upon arrival.
Ideal for Hardwood Substrates
Pink Oyster grows optimally on hardwood-based substrates, supporting strong and healthy mycelium development.
Easy to Use
Plate cultures are accessible for all experience levels, from beginners to advanced growers.
Usage & application
Agar plates are versatile and can be used to create master bags, inoculate grain or bulk substrates, make liquid cultures, or produce additional plates. For best results, use a still-air box or laminar flow hood to keep sterility while transferring to substrates or creating additional cultures. Agar plates are an invaluable tool in mushroom cultivation, providing a stable and adaptable foundation for mycelium propagation, strain preservation, and research, essential for both hobbyists and professional cultivators.
Add bold color and fast growth to your setup with our Pink Oyster Mushroom Agar Plate. This vibrant strain (Pleurotus djamor) is known for its striking rose-pink clusters, warm-temperature tolerance, and incredibly quick colonization. Pink Oysters offer a rich, meaty aroma and produce beautiful, coral-like formations that stand out in any grow room. Perfect for beginners and seasoned growers looking for a reliable, visually stunning variety.
Why you'll love it
High Quality Formulation
Our cultures are made-to-order in our in-house lab using premium genetics and medical-grade petri dishes. Each culture is suspended in nutrient-rich malt extract agar, ideal for vigorous mycelial growth.
Lab-Tested Purity
Cultured under rigorous lab conditions to ensure a 100% contaminant-free experience, backed by our award-winning genetics.
Expert Quality Control
QC'd by our team of expert mycologists, each culture is individually wrapped to ensure freshness and sterility upon arrival.
Ideal for Hardwood Substrates
Pink Oyster grows optimally on hardwood-based substrates, supporting strong and healthy mycelium development.
Easy to Use
Plate cultures are accessible for all experience levels, from beginners to advanced growers.
Usage & application
Agar plates are versatile and can be used to create master bags, inoculate grain or bulk substrates, make liquid cultures, or produce additional plates. For best results, use a still-air box or laminar flow hood to keep sterility while transferring to substrates or creating additional cultures. Agar plates are an invaluable tool in mushroom cultivation, providing a stable and adaptable foundation for mycelium propagation, strain preservation, and research, essential for both hobbyists and professional cultivators.
Add bold color and fast growth to your setup with our Pink Oyster Mushroom Agar Plate. This vibrant strain (Pleurotus djamor) is known for its striking rose-pink clusters, warm-temperature tolerance, and incredibly quick colonization. Pink Oysters offer a rich, meaty aroma and produce beautiful, coral-like formations that stand out in any grow room. Perfect for beginners and seasoned growers looking for a reliable, visually stunning variety.
Why you'll love it
High Quality Formulation
Our cultures are made-to-order in our in-house lab using premium genetics and medical-grade petri dishes. Each culture is suspended in nutrient-rich malt extract agar, ideal for vigorous mycelial growth.
Lab-Tested Purity
Cultured under rigorous lab conditions to ensure a 100% contaminant-free experience, backed by our award-winning genetics.
Expert Quality Control
QC'd by our team of expert mycologists, each culture is individually wrapped to ensure freshness and sterility upon arrival.
Ideal for Hardwood Substrates
Pink Oyster grows optimally on hardwood-based substrates, supporting strong and healthy mycelium development.
Easy to Use
Plate cultures are accessible for all experience levels, from beginners to advanced growers.
Usage & application
Agar plates are versatile and can be used to create master bags, inoculate grain or bulk substrates, make liquid cultures, or produce additional plates. For best results, use a still-air box or laminar flow hood to keep sterility while transferring to substrates or creating additional cultures. Agar plates are an invaluable tool in mushroom cultivation, providing a stable and adaptable foundation for mycelium propagation, strain preservation, and research, essential for both hobbyists and professional cultivators.
Product details & instructions
Explore our full lineup of genetics
Strains that love hardwood as much as growers love big harvests.